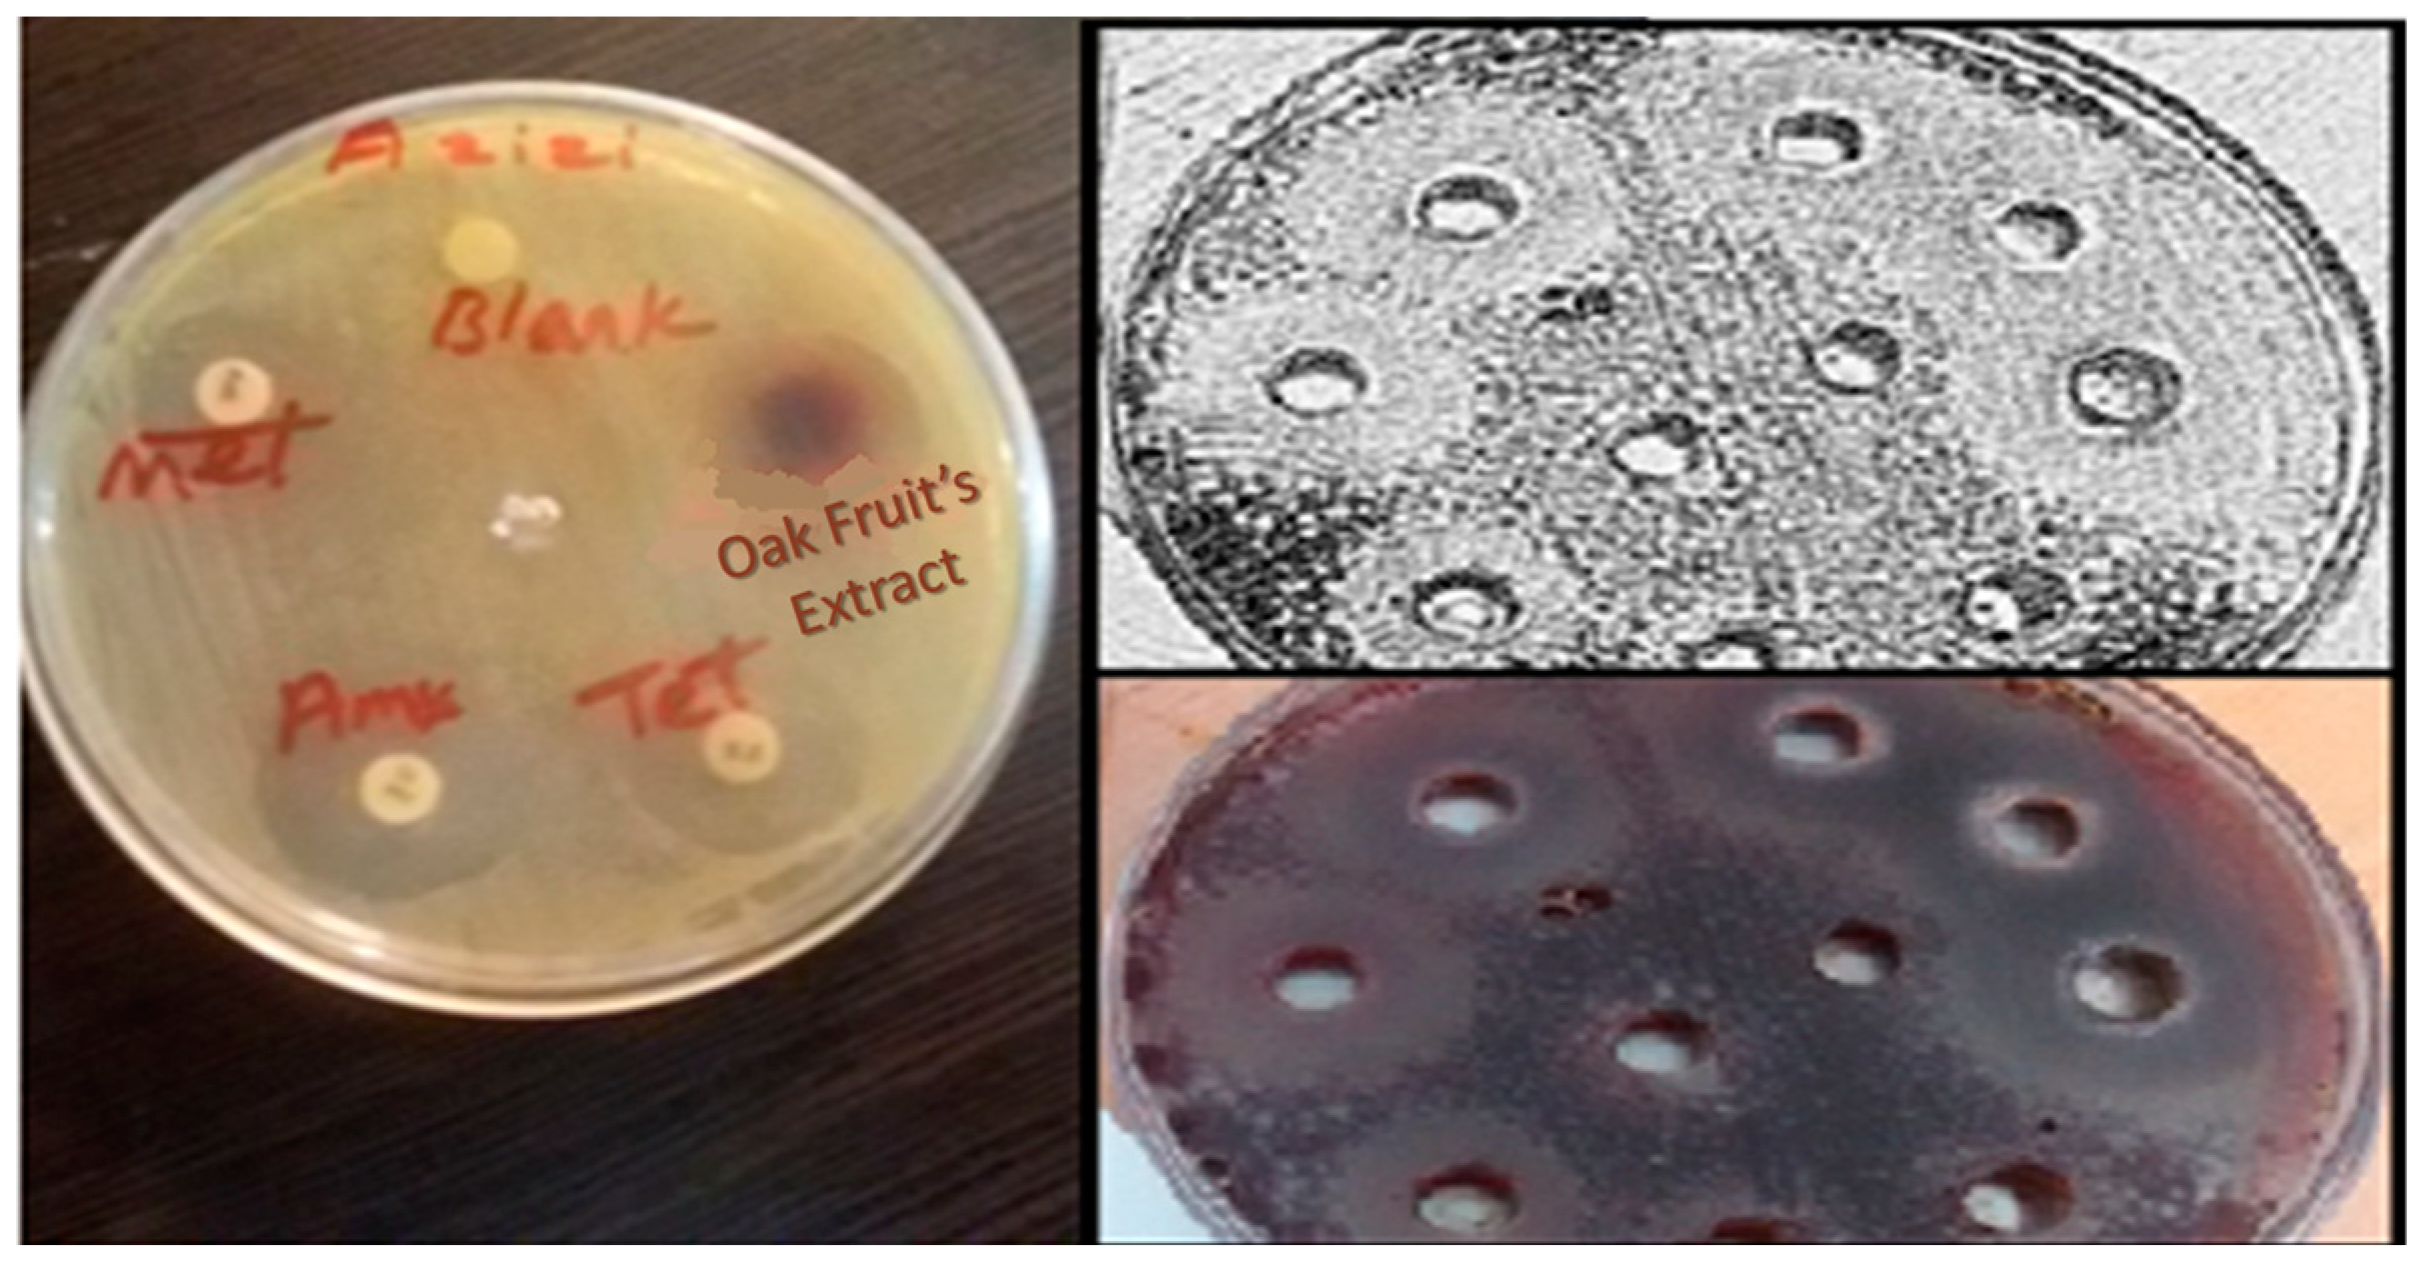
Catalysts 12 01027 g006

Antibacterial Activity Assessment of Bi2WO6/Ag3PO4/Ag Photocatalyst and Persian Oak fruit Phytobiotic
Abstract
:1. Introduction
2. Results and Discussion
2.1. Characterization of Prepared Samples
2.2. Photocatalytic Inactivation Mechanism
2.3. MIC and MBC Results
2.4. PCR for Various Gene Confirmations
2.5. Evaluation of Real-Time PCR
2.6. PCR to Determine Urease Gene
2.7. Determination of the Amount of the Urease Gene Expression in the Presence of the Photocatalyst and the Oak fruit Extract
2.8. Comparison of the ZOI of the Treatments
3. Materials and Methods
3.1. Reagents
3.2. Bi2WO6/Ag3PO4/Ag Photocatalyst Preparation
3.3. Culture
3.4. Oak fruit’s Extraction
3.5. Antioxidant Activity
3.6. Antimicrobial Susceptibility Testing Method
3.6.1. Antibiotic Sensitivity of H. pylori Strains
3.6.2. The Termination of the Zone of Inhibition for an Extract of Oak fruit and Blue-Light-Driven Photocatalyst
3.6.3. Effectiveness of Bactericidal Performance of an Extract of Oak fruit and Blue-Light-Driven Photocatalyst
3.7. Treatment of H. pylori with Photocatalyst under the Conditions of Blue-Light-Driven Photocatalyst and Oak fruit Extract
3.8. RNA Extraction and cDNA Preparation
3.9. Real-Time PCR
3.9.1. PCR to Confirm Urease Gene
3.9.2. Sample Preparation for PCR Amplification
4. Conclusions
Author Contributions
Funding
Acknowledgments
Conflicts of Interest
References
- Liburd, L.C.; Hall, J.E.; Mpofu, J.J.; Williams, S.M.; Bouye, K.; Penman-Aguilar, A. Addressing health equity in public health practice: Frameworks, promising strategies, and measurement considerations. Annu. Rev. Public Health 2020, 41, 417–432. [Google Scholar] [CrossRef] [PubMed]
- Nowacka, M.; Rygała, A.; Kręgiel, D.; Kowalewska, A. Poly (silsesquioxanes) and poly (siloxanes) grafted with N-acetylcysteine for eradicating mature bacterial biofilms in water environment. Colloids Surf. B Biointerfaces 2018, 172, 627–634. [Google Scholar] [CrossRef] [PubMed]
- Tortajada, C.; van Rensburg, P. Drink More Recycled Wastewater; Nature Publishing Group: London, UK, 2020. [Google Scholar]
- Kumar, R.; Raizada, P.; Verma, N.; Hosseini-Bandegharaei, A.; Thakur, V.K.; Van Le, Q.; Nguyen, V.-H.; Selvasembian, R.; Singh, P. Recent advances on water disinfection using bismuth based modified photocatalysts: Strategies and challenges. J. Clean. Prod. 2021, 297, 126617. [Google Scholar] [CrossRef]
- Šterbenc, A.; Jarc, E.; Poljak, M.; Homan, M. Helicobacter pylori virulence genes. World J. Gastroenterol. 2019, 25, 4870. [Google Scholar] [CrossRef] [PubMed]
- Graham, D.Y.; Miftahussurur, M. Helicobacter pylori urease for diagnosis of Helicobacter pylori infection: A mini review. J. Adv. Res. 2018, 13, 51–57. [Google Scholar] [CrossRef]
- Priyadarsini, S.; Mukherjee, S.; Bag, J.; Nayak, N.; Mishra, M. Application of nanoparticles in dentistry: Current trends. In Nanoparticles in Medicine; Springer: Berlin/Heidelberg, Germany, 2020; pp. 55–98. [Google Scholar]
- Amiri, M.; Dashtian, K.; Ghaedi, M.; Mosleh, S.; Jannesar, R. Bi2WO6/Ag3PO4–Ag Z-scheme heterojunction as a new plasmonic visible-light-driven photocatalyst: Performance evaluation and mechanism study. New J. Chem. 2019, 43, 1275–1284. [Google Scholar] [CrossRef]
- Razaghi, P.; Dashtian, K.; Yousefi, F.; Karimi, R.; Ghaedi, M. Gold anchoring to CuFe2F8(H2O)2 oxyfluoride for robust sono-photodegradation of Rhodamine-B. J. Clean. Prod. 2021, 313, 127916. [Google Scholar] [CrossRef]
- Zhao, W.; Zhang, J.; Zhu, F.; Mu, F.; Zhang, L.; Dai, B.; Xu, J.; Zhu, A.; Sun, C.; Leung, D.Y. Study the photocatalytic mechanism of the novel Ag/p-Ag2O/n-BiVO4 plasmonic photocatalyst for the simultaneous removal of BPA and chromium (VI). Chem. Eng. J. 2019, 361, 1352–1362. [Google Scholar] [CrossRef]
- Liu, Y.; Kong, J.; Yuan, J.; Zhao, W.; Zhu, X.; Sun, C.; Xie, J. Enhanced photocatalytic activity over flower-like sphere Ag/Ag2CO3/BiVO4 plasmonic heterojunction photocatalyst for tetracycline degradation. Chem. Eng. J. 2018, 331, 242–254. [Google Scholar] [CrossRef]
- Dashtian, K.; Shahbazi, S.; Tayebi, M.; Masoumi, Z. A review on metal-organic frameworks photoelectrochemistry: A headlight for future applications. Coord. Chem. Rev. 2021, 445, 214097. [Google Scholar]
- Wen, X.-J.; Niu, C.-G.; Zhang, L.; Liang, C.; Guo, H.; Zeng, G.-M. Photocatalytic degradation of ciprofloxacin by a novel Z-scheme CeO2–Ag/AgBr photocatalyst: Influencing factors, possible degradation pathways, and mechanism insight. J. Catal. 2018, 358, 141–154. [Google Scholar] [CrossRef]
- Shamloufard, A.; Hajati, S.; Youzbashi, A.; Dashtian, K.; Moradi, M.; Toth, J. S-scheme NIR-edge Ag3CuS2/VO2 heterostructure for photo-oxidation/reduction of methylene blue/Cr (VI). Appl. Surf. Sci. 2022, 590, 153118. [Google Scholar] [CrossRef]
- Adeeyo, A.O.; Edokpayi, J.N.; Alabi, M.A.; Msagati, T.A.; Odiyo, J.O. Plant active products and emerging interventions in water potabilisation: Disinfection and multi-drug resistant pathogen treatment. Clin. Phytoscience 2021, 7, 31. [Google Scholar] [CrossRef]
- Saquib, S.A.; AlQahtani, N.A.; Ahmad, I.; Kader, M.A.; Al Shahrani, S.S.; Asiri, E.A. Evaluation and comparison of antibacterial efficacy of herbal extracts in combination with antibiotics on periodontal pathobionts: An in vitro microbiological study. Antibiotics 2019, 8, 89. [Google Scholar] [CrossRef] [PubMed]
- Aidy, A.; Bahmani, M.; Pirhadi, M.; Kaviar, V.H.; Karimi, E.; Abbasi, N. Phytochemical Analysis and Antimicrobial Effect of Essential Oil and Extract of Loranthus europaeus Jacq. on Acinetobacter baumannii, Staphylococcus aureus, and Pseudomonas aeruginosa. Kafkas Univ. Vet. Fak. Derg. 2022, 28, 26626. [Google Scholar]
- Dehelean, C.A.; Marcovici, I.; Soica, C.; Mioc, M.; Coricovac, D.; Iurciuc, S.; Cretu, O.M.; Pinzaru, I. Plant-derived anticancer compounds as new perspectives in drug discovery and alternative therapy. Molecules 2021, 26, 1109. [Google Scholar] [CrossRef]
- Salehi, B.; Sharopov, F.; Martorell, M.; Rajkovic, J.; Ademiluyi, A.O.; Sharifi-Rad, M.; Fokou, P.V.T.; Martins, N.; Iriti, M.; Sharifi-Rad, J. Phytochemicals in Helicobacter pylori infections: What are we doing now? Int. J. Mol. Sci. 2018, 19, 2361. [Google Scholar] [CrossRef]
- Naseri, H.; Sharifi, A.; Ghaedi, M.; Dashtian, K.; Khoramrooz, S.S.; Manzouri, L.; Khosravani, S.A.; Pezeshkpour, V.; Sadri, F.; Askarinia, M. Sonochemical incorporated of cytosine in Cu-H2bpdc as an antibacterial agent against standard and clinical strains of Proteus mirabilis with rsbA gene. Ultrason. Sonochem. 2018, 44, 223–230. [Google Scholar] [CrossRef] [PubMed]
- Opekun, A.R.; Zierold, C.; Rode, A.; Blocki, F.A.; Fiorini, G.; Saracino, I.M.; Vaira, D.; Sutton, F.M. Clinical performance of the automated LIAISON® meridian H. pylori SA stool antigen test. BioMed Res. Int. 2020, 2020, 7189519. [Google Scholar] [CrossRef]
- Mwinyikombo, I.S. Isolation, Antibiotic Susceptibility and Molecular Characterisation of Resistance Genes in Pseudomonas Isolates from Selected Hospitals in Mombasa County; Kenyatta University: Nairobi, Kenya, 2018. [Google Scholar]
- Ghotaslou, R.; Pirzadeh, T.; Esmailkhani, A.; Bialvaei, A.Z.; Leylabadlo, H.E. Recent advances in the diagnosis of Helicobacter pylori infection. J. Sabzevar Univ. Med. Sci. 2022, 29, 179–194. [Google Scholar]
- Rey, L. Revista do Instituto de Medicina Tropical de São Paulo (Journal of the São Paulo Institute of Tropical Medicine) fifty years later. Rev. Inst. Med. Trop. São Paulo 2009, 51, 239–240. [Google Scholar] [CrossRef] [PubMed]
- De Sotillo, D.R.; Hadley, M.; Holm, E. Phenolics in aqueous potato peel extract: Extraction, identification and degradation. J. Food Sci. 1994, 59, 649–651. [Google Scholar] [CrossRef]
- Yang, J.; Chen, J.; Hao, Y.; Liu, Y. Identification of the DPPH radical scavenging reaction adducts of ferulic acid and sinapic acid and their structure-antioxidant activity relationship. LWT 2021, 146, 111411. [Google Scholar] [CrossRef]
- Zou, Y.; Qian, X.; Liu, X.; Song, Y.; Song, C.; Wu, S.; An, Y.; Yuan, R.; Wang, Y.; Xie, Y. The effect of antibiotic resistance on Helicobacter pylori eradication efficacy: A systematic review and meta-analysis. Helicobacter 2020, 25, e12714. [Google Scholar] [CrossRef]
- Abbasloo, F.; Khosravani, S.A.; Ghaedi, M.; Dashtian, K.; Hosseini, E.; Manzouri, L.; Khorramrooz, S.S.; Sharifi, A.; Jannesar, R.; Sadri, F. Sonochemical-solvothermal synthesis of guanine embedded copper based metal-organic framework (MOF) and its effect on oprD gene expression in clinical and standard strains of Pseudomonas aeruginosa. Ultrason. Sonochem. 2018, 42, 237–243. [Google Scholar] [CrossRef]
- Musini, A.; Chilumoju, S.P.; Giri, A. Biofilm Formation in Drug-Resistant Pathogen Staphylococcus aureus. In Microbial Biofilms; CRC Press: Boca Raton, FL, USA, 2022; pp. 23–46. [Google Scholar]

| Bacterial Strain | Oak fruit (mg/mL) | Bi2WO6/Ag3PO4/Ag (mg/mL) | Mixed (mg/mL) | |
|---|---|---|---|---|
| Oak fruit | Bi2WO6/Ag3PO4/Ag | |||
| H. pylori (ATCC 26695) | 3.1 | 0.6 | 1.55 | 0.3 |
| Clinical strain | 3.1 | 0.8 | 3.1 | 0.8 |
| Compounds | Concentration |
|---|---|
| Master mix | 12.5 mg (1×) |
| Distill water | 9.0 mg |
| Template | 2.5 mg (20pg) |
| Primer forward | 0.5 mg (10 μM) |
| Primer reverse | 0.5 mg (10 μM) |
| Primer | Sequence | Amplicon (bp) | Tm |
|---|---|---|---|
| Urease-F | ′5-GCCAATGGTAAATTAGTT-3′ | 245 | 58 |
| Urease-R | ′5-CTCCTTAATTGTTTTTAC-3′ | 58 | |
| gyrB-F | ′5-GACCCGTACGCTAAACAAC-3′ | 110 | 63.3 |
| gyrB-R | ′5-AGAAATAACCGCAATCAGG-3′ | 66.4 |
| Gene | Initial Denaturation | Secondary Denaturation | Primer Connecting | Primer Duplication | Final Duplication |
|---|---|---|---|---|---|
| Urease A | 95 | 95 | 60 | 72 | 72 |
| 15 min | 15 s | 30 s | 40 s | 7 min |
| Type of Intervention | Extract of Oak fruit in Concentration MIC | Bi2WO6/Ag3PO4/Ag in Concentration MIC | Mixed Oak fruit Extract and Bi2WO6/Ag3PO4/Ag in Concentration MIC | |
|---|---|---|---|---|
| Strain Studied | ||||
| H. pylori (ATCC 26695) | 0.06% | 0.53% | 31% | |
| Average of gene expression for 5 Clinical strains | 11% | 9% | 42% | |
| Standard | Calibration (mg/mL−1) | IC50 ± SD |
|---|---|---|
| DPPH | Y = 46.124 x + 8.6987 | 61.7 ± 0.04 |
| Antibiotics | Sensitive | Intermediate | Resistant | |||
|---|---|---|---|---|---|---|
| Number | Percent | Number | Percent | Number | Percent | |
| Amoxicillin (25 mcg) | 39 | 74% | - | - | 14 | 26% |
| Tetracycline (30 mcg) | 43 | 81% | 3 | 6% | 7 | 13% |
| Metronidazole (5 mcg) | 4 | 7% | - | - | 49 | 92% |
| Clarithromycin (15 mcg) | 37 | 70% | 6 | 11% | 10 | 19% |
| Target (Reference), Nucleotide (nt) Positions Amplified, and Size of PCR Products | Primer Names and Sequences | PCR Conditions (One Minute) |
|---|---|---|
| urease gene [26], nt 304–714, 411 bp | Urease, 5′-GCCAATGGTAAATTAGTT-3′ | 94 °C; 45 °C; 72 °C (38 cycles) |
| Urease, 5′-CTCCTTAATTGTTTTTAC-3′ |
| Target (Reference), Nucleotide (nt) Positions Amplified, and Size of PCR Products | Primer Names and Sequences | PCR Conditions (One Minute) |
|---|---|---|
| 16S rRNA [27] nt 635–744, 110 bp | Hp-1, 5′- CTGGAGAGACTAAGCCCTCC-3′ | 95 °C; 58 °C; 72 °C, (30 cycles) |
Publisher’s Note: MDPI stays neutral with regard to jurisdictional claims in published maps and institutional affiliations. |
© 2022 by the authors. Licensee MDPI, Basel, Switzerland. This article is an open access article distributed under the terms and conditions of the Creative Commons Attribution (CC BY) license (https://creativecommons.org/licenses/by/4.0/).
Share and Cite
Azizi, M.; Dashtian, K.; Amourizi, F.; Sharifi, A.; Ghaedi, M.; Pezeshkpour, V.; Azizi, A.; Aghaee, S.; Khosravani, S.A.; Yasin, G. Antibacterial Activity Assessment of Bi2WO6/Ag3PO4/Ag Photocatalyst and Persian Oak fruit Phytobiotic. Catalysts 2022, 12, 1027. https://doi.org/10.3390/catal12091027
Azizi M, Dashtian K, Amourizi F, Sharifi A, Ghaedi M, Pezeshkpour V, Azizi A, Aghaee S, Khosravani SA, Yasin G. Antibacterial Activity Assessment of Bi2WO6/Ag3PO4/Ag Photocatalyst and Persian Oak fruit Phytobiotic. Catalysts. 2022; 12(9):1027. https://doi.org/10.3390/catal12091027
Chicago/Turabian StyleAzizi, Mohsen, Kheibar Dashtian, Fereshteh Amourizi, Asghar Sharifi, Mehrorang Ghaedi, Vahid Pezeshkpour, Arsalan Azizi, Shapor Aghaee, Seyed Abdolmajid Khosravani, and Ghulam Yasin. 2022. "Antibacterial Activity Assessment of Bi2WO6/Ag3PO4/Ag Photocatalyst and Persian Oak fruit Phytobiotic" Catalysts 12, no. 9: 1027. https://doi.org/10.3390/catal12091027
APA StyleAzizi, M., Dashtian, K., Amourizi, F., Sharifi, A., Ghaedi, M., Pezeshkpour, V., Azizi, A., Aghaee, S., Khosravani, S. A., & Yasin, G. (2022). Antibacterial Activity Assessment of Bi2WO6/Ag3PO4/Ag Photocatalyst and Persian Oak fruit Phytobiotic. Catalysts, 12(9), 1027. https://doi.org/10.3390/catal12091027

